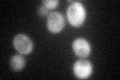
YER007C-A
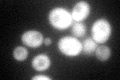
YER007C-A
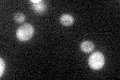
YER007C-A

View description
Protein of unknown function that associates with ribosomes and has a putative RNA binding domain; interacts with Tma22p; null mutant exhibits translation defects; has homology to human oncogene MCT-1
Localization:
Intensity:
Fold change:
Significance:
-
C’ GFP library in SD
cytosol68.95 -
N' NOP1pr-GFP in SD

N/A0 -
N' TEF2pr-mCherry in SD

N/A0 -
N' NATIVEpr-GFP in SD

N/A0 -
N' TEF2pr-VC and Cyto-VN in SD

N/A0 -
C’ GFP library in SD+DTT
cytosol61.010.88No -
C’ GFP library in SD+H2O2

cytosol62.10.9No -
C’ GFP library in Starvation Media
cytosol47.930.69No -
C’ GFP library on the background of Pup2-DaMP

cytosol -
C’ GFP library on the background of CCT mutant

cytosol65.39410.948194No
